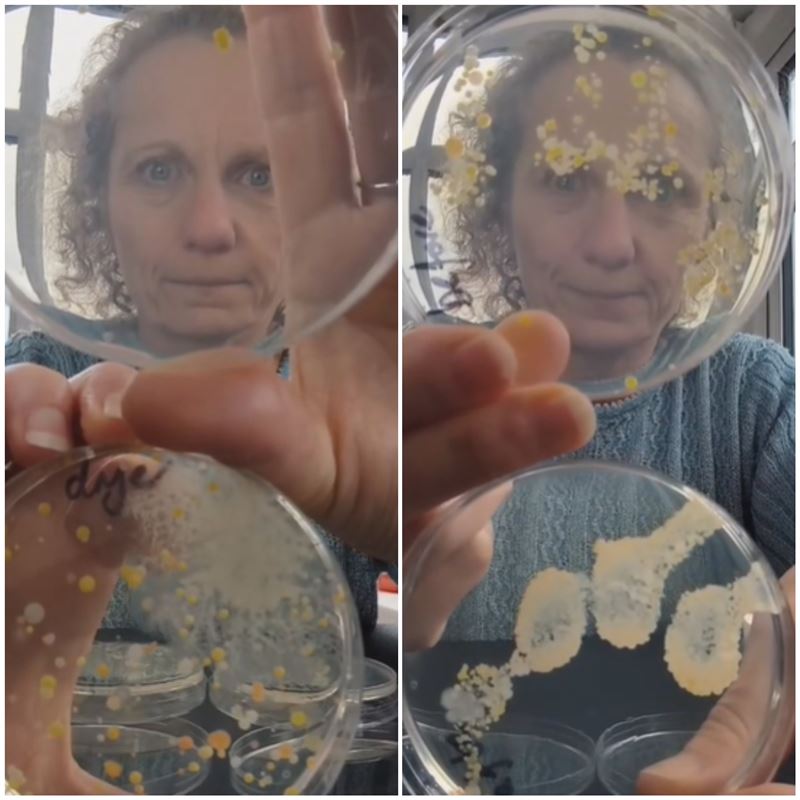
英國教育機構實驗，烘手機吹出的風（左下）、在廁所裡揮一揮（左上）、洗手前的手（右上）、洗手完再用烘手機烘乾的手（右下），個別放培養皿中細菌的生長結果。（圖／翻攝自抖音＠devonscience）

生活中心/倪譽瑋報導
英國教育機構實驗,烘手機吹出的風(左下)、在廁所裡揮一揮(左上)、洗手前的手(右上)、洗手完再用烘手機烘乾的手(右下),個別放培養皿中細菌的生長結果。(圖/翻攝自抖音@devonscience)
英國教育機構實驗,烘手機吹出的風(左下)、在廁所裡揮一揮(左上)、洗手前的手(右上)、洗手完再用烘手機烘乾的手(右下),個別放培養皿中細菌的生長結果。(圖/翻攝自抖音@devonscience)洗手注意!日前英國專家針對烘手機與廁所中的細菌量展開實驗,結果顯示烘手機吹出的風細菌含量極高,即使手洗完了,吹乾後的細菌量仍和未洗手前一樣。影片讓數千萬人驚呼「以後不敢用了」;也有部分人提出,實驗並不嚴謹,烘手機清潔程度不明、也沒測試擦手紙的細菌量。台灣醫師則認為,擦手紙或烘手機其實都可以,要避免手部過量細菌的關鍵,在擦乾(烘乾)前的洗手步驟要確實。
英國實驗曝:廁所中烘手機出風細菌量最高
先前英國教育機構「Devon Science」曾指出,烘手機吹出的風其實細菌量很高,機構的專家Ruth MacLaren進行實驗,將培養皿放在廁所的烘手機出風口,吹完後再等細菌生長,結果發現數量非常多。
如今Ruth MacLaren再進行對照實驗,拿了4個培養皿,採集烘手機出風口、廁所大空間(用培養皿在空中晃一晃)、洗手前的手、洗完手後用烘手機的手,這4處的細菌。結果發現,廁所中的空氣細菌量很少,反而是烘手機出風口吹出的長了滿滿細菌。
網友震驚洗手後不敢再用 也有人質疑實驗不嚴謹
值得注意的是,洗手前的手培養出的細菌量稍多;而洗完手後再用烘手機,細菌量竟然和沒洗過差不多。目前實測影片已破1000萬人觀看,許多網友驚呼「所以我最好還是擦乾它們(手)」「好吧,我以後再也不用烘手機了」;也有人提出實驗不嚴謹,「需要測試一下洗手後自然晾乾,看看手上是否有細菌」、「沒測用紙巾擦乾」。
影片也被轉發至社群平台Threads,網友們驚呼「謝謝,以後不烘乾手了」、「我知道烘乾機烘完手後沒有比較乾淨,所以我洗完手從不用烘乾機」;也有人認為不必過於擔心,「一般正常人本來就該為了健康常洗手,所以手不會像培養皿一樣放好幾天長出黴菌」、「烘手機的風吹出來會長菌是事實,但不等於烘手機內部很髒」。
台灣醫師的看法?
過去台大醫院兒童感染科醫師李秉穎曾提出,用擦手紙比烘手機好,主要是因為細菌、病毒會附著在手上,擦手紙可以產生物理摩擦作用,有較好除菌效果。但不論使用烘手機還是擦手紙,手部清潔的關鍵,應在於洗手時要有足夠的摩擦,透過搓洗達到移除病毒的目的,若是洗手步驟有做好「使用烘手機是沒有太大問題的」。
長庚醫院毒物科醫師顏宗海則提醒,雖然在廁所被殘存病菌感染致病的可能性不高,但就怕烘手機清洗不確實,反而藏了一堆細菌,「如果不乾淨的烘手機,也擔心會藏汙納垢」使用前可留意機器是否有清潔乾淨。
 5 顆
5 顆  10 顆
10 顆  15 顆
15 顆  20 顆
20 顆